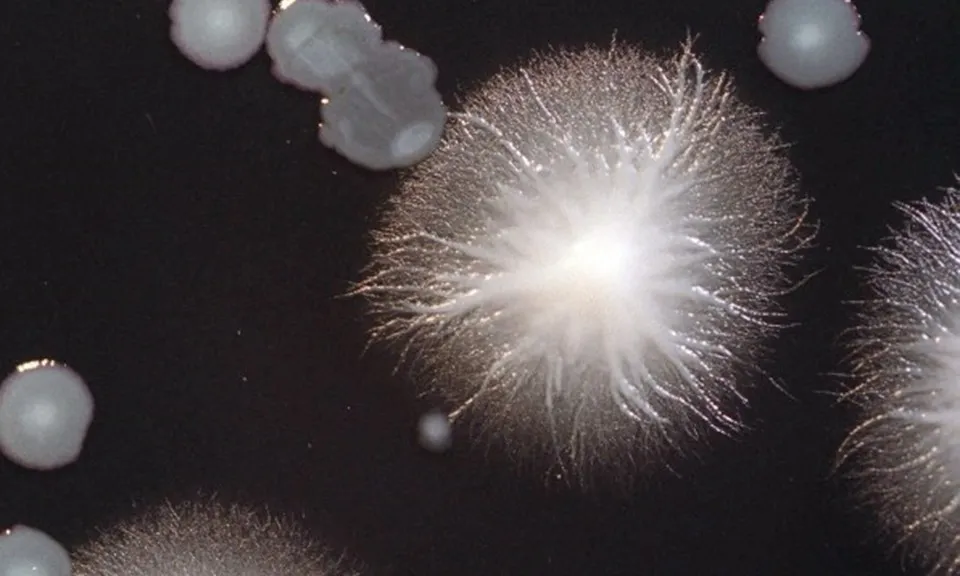
Dạng viêm phổi nghiêm trọng lây lan khắp thành phố Melbourne

Sở Y tế Victoria cho biết, họ tin rằng đã xác định được nguồn gốc của đợt bùng phát dịch bệnh chết người ở Melbourne.
Các trường hợp đầu tiên bắt đầu tăng đột biến vào cuối tháng 7 và cho đến nay đã có 78 trường hợp được xác nhận và 10 trường hợp nghi ngờ mắc bệnh viêm phổi dạng nặng.
Hầu như tất cả những người bị ảnh hưởng đều phải nhập viện, phần lớn bệnh nhân là người lớn trên 40 tuổi. Trong đó, 1 người đàn ông ngoài 60 tuổi và 1 người phụ nữ ngoài 90 tuổi đã tử vong vào tuần trước sau khi mắc bệnh.

Cuộc điều tra về đợt bùng phát trong những ngày gần đây đã thu hẹp phạm vi tại khu vực Derrimut và North Laverton. Chính quyền tiến hành xét nghiệm và khử trùng các tháp làm mát tại địa phương một cách tỉ mỉ.
Ngày 5/8, Tiến sĩ Clare Looker, Giám đốc Y tế tiểu bang cho biết, một trong những tòa tháp mà cơ quan này đã thử nghiệm và khử trùng - trong quá trình điều tra đã trả về kết quả mẫu dương tính với vi khuẩn Legionella.
Bệnh thường biểu hiện dưới dạng nhiễm trùng ngực và do một loại vi khuẩn có tên là Legionella gây ra - vi khuẩn được tìm thấy trong các nguồn nước tự nhiên như hồ và sông.
Tuy nhiên, nó cũng có thể bắt nguồn từ các hệ thống nhân tạo sử dụng nước để sưởi ấm và làm mát.
Tiến sĩ Looker cho biết vẫn còn nhiều việc phải làm để hiểu nguyên nhân gây bùng phát dịch bệnh trong tháp giải nhiệt.
Bà cho biết: “Đây là kết quả sơ bộ, vì vậy vẫn còn rất nhiều việc phải làm, chúng tôi chưa dừng lại, vẫn còn nhiều việc phải làm và cần phải điều tra thêm để hiểu lý do tại sao vi khuẩn Legionella lại phát triển trong tháp giải nhiệt đó”.
Chuyên gia dịch tễ học, Giáo sư Catherine Bennett chỉ ra, thời điểm bắt đầu bùng phát dịch bệnh và thời tiết lạnh giá, sương mù mà Melbourne trải qua vào tháng 7.
“Điều đó giúp đưa hơi nước từ các tháp giải nhiệt xuống mặt đất hoặc vào các cửa hút gió khác. Và làm tăng nguy cơ bùng phát dịch bệnh”, bà nói với Sky News Australia.
Bệnh Legionnaires là gì?
Bệnh Legionnaires là một dạng viêm phổi nghiêm trọng do một loại vi khuẩn có tên là Legionella gây ra
Người lớn tuổi, người hút thuốc và những người có hệ miễn dịch suy yếu đặc biệt dễ mắc bệnh Legionnaires.
Bệnh Legionnaires có thể gây tử vong nhưng điều trị kịp thời bằng thuốc kháng sinh thường chữa khỏi bệnh
Các triệu chứng như thế nào?
Các triệu chứng bao gồm sốt, ớn lạnh, ho, đau đầu và đau nhức cơ thể.
Bệnh lây lan như thế nào?
Hầu hết mọi người bị nhiễm bệnh khi hít phải những giọt nước cực nhỏ có chứa vi khuẩn Legionella
Các đợt bùng phát đã được liên kết với:
- Tháp giải nhiệt trong hệ thống điều hòa không khí
- Bình nước nóng và máy sưởi
- Bồn tắm nước nóng và bồn sục
- Đài phun nước trang trí
- Bể bơi
- Uống nước